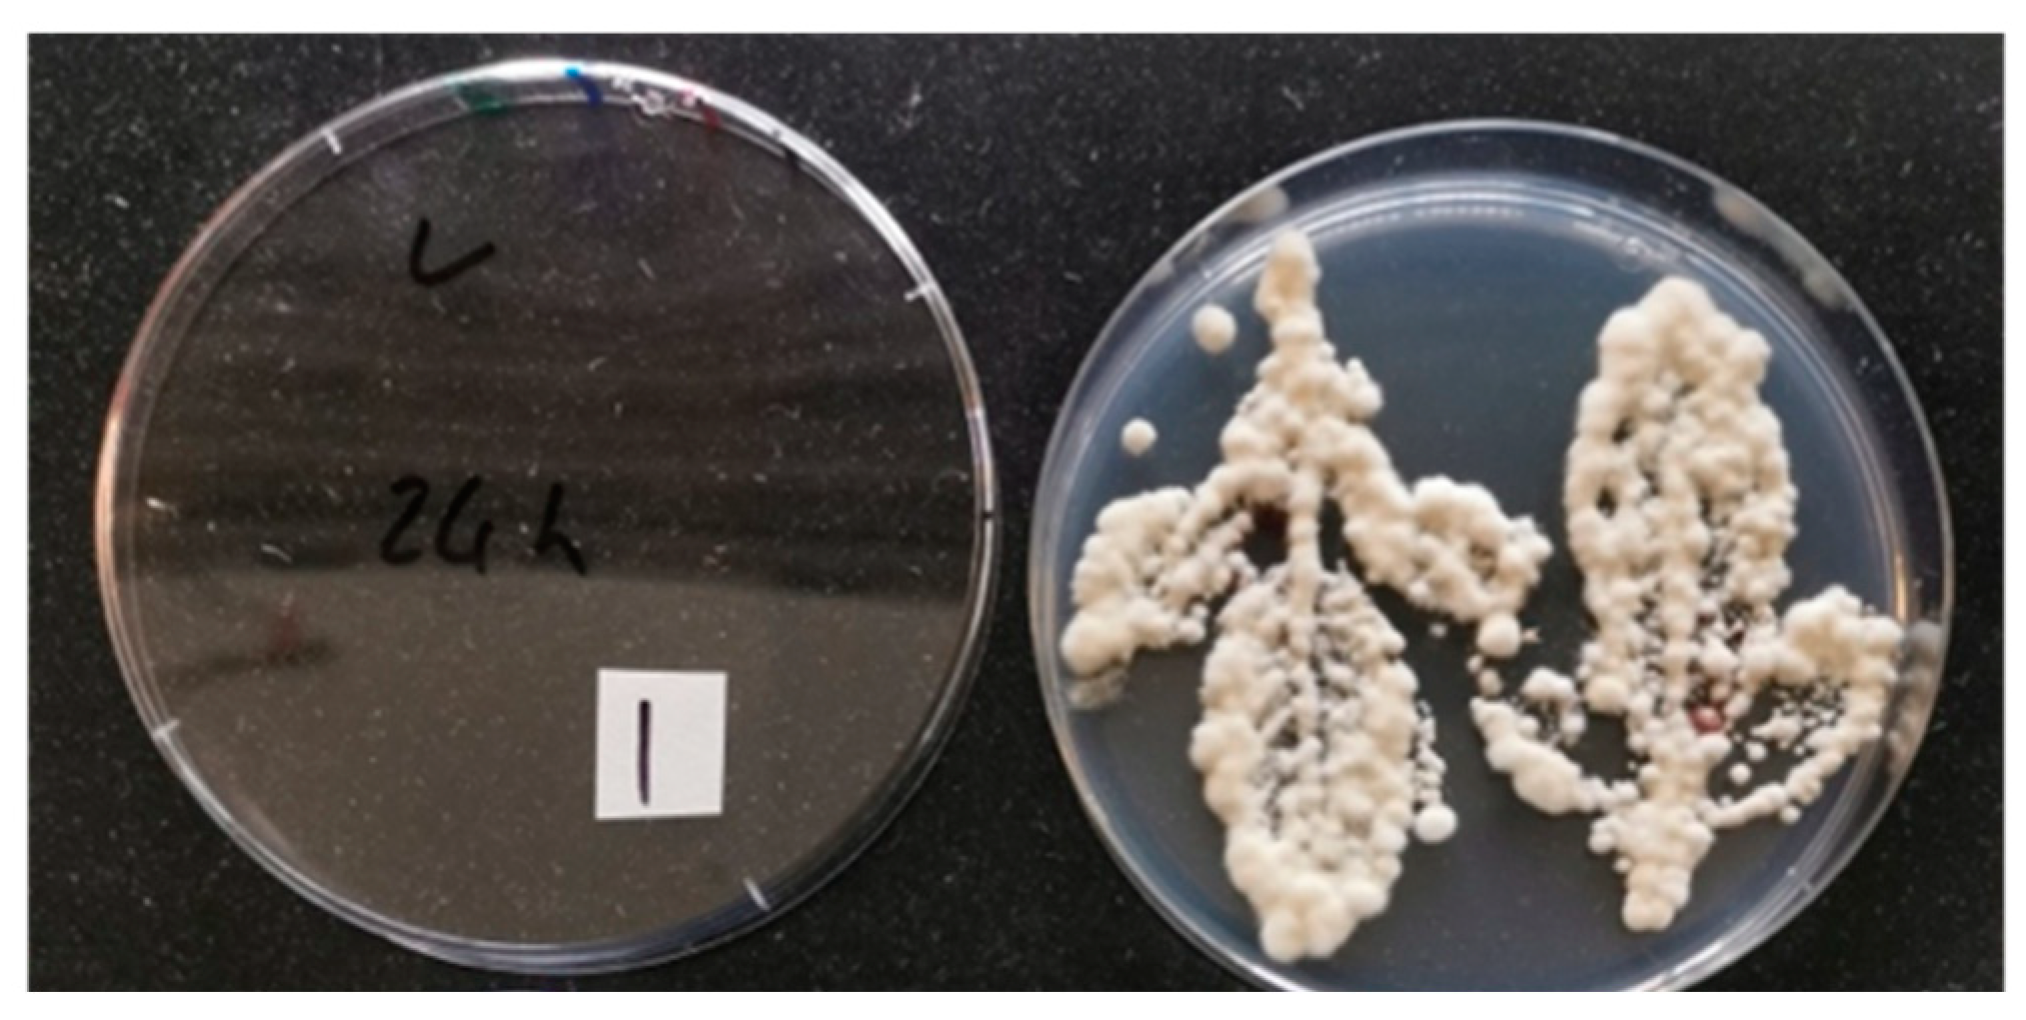
Applmicrobiol 02 00044 g002

Abstract
The citrus industry is challenged by numerous arthropods, yet extensive research has not been conducted to determine the potential use of entomopathogenic fungi as endophytes in pest management strategies. Two inoculation methods (i.e., soil drench and foliar spray) using a suspension of Beauveria bassiana (strain PPRI 5339 contained in Velifer®) containing 4 × 107 conidia mL−1 in 0.01% Tween 80 were conducted on three commercially available citrus rootstocks (i.e., ‘US-942’, ‘US-812’, ‘Swingle’). Seedlings were grown under greenhouse-controlled conditions over a 7-week observation period. Similarly, a third inoculation method (seed soaking) was conducted using seeds from the same three rootstocks. The fungus was re-isolated post-inoculation from ‘US-942’ and ‘US-812’ in the foliar spray and seed soaking treatments. In addition, the fungus was recovered from root tissue in the foliar-sprayed seedlings, suggesting possible systemic movement from leaves to roots. The fungus was not recovered from soil-drench-treated seedlings, nor from any of the ‘Swingle’ cultivars. This study assessed the potential of B. bassiana to endophytically colonize certain citrus rootstocks in planta.
1. Introduction
Entomopathogenic fungi (EPF) are types of fungi that are parasitic to arthropods [1]. Fungal propagules in contact with the arthropods cuticle first germinate, and then form an appressorium, followed by a penetration peg. The fungus produces chitinase and other enzymes to break down the cuticle. This leads to continued hyphal growth through the cuticle until it reaches the hemocoel, where it produces hyphal bodies (or blastospores), eventually forming a mycelial mass and killing the arthropod [2,3]. Some species release mycotoxins, such as beauvericin, that can injure or kill the insect before mycosis fully takes place [3]. When conditions are favorable, the fungus forms conidiophores on the surface of the arthropod’s body, which release spores for new infections [4,5]. Commercially available EPF-based biopesticides are being used as an alternative to synthetic chemical insecticides, since they can have negative health, environmental, ecological, and economic consequences [4,6]. EPF-based biopesticides, however, have some drawbacks as well, e.g., decreased efficacy when exposed to ultraviolet light and low percent relative humidity, non-compatible interactions when mixed with other insecticides during field application, and relatively short-term persistence [7]. To circumvent these issues, an alternative approach utilizing EPF as endophytes has received increased research attention over the past decade [8].
Fungal endophytes are microorganisms that live within plant tissues (in planta); they are common, diverse, symbiotic, and potentially mutualistic, especially among entomopathogenic species [9]. It is believed that most plant species in natural ecosystems contain fungal endophytes, with woody species having hundreds or even thousands of species [9,10]. While most are merely symbiotic, EPF can provide the plant with distinct benefits, particularly increased resistance to arthropods. The artificial inoculation of plants with entomopathogenic fungi has shown to be useful in controlling arthropod pests, promoting plant growth, and increasing tolerance to plant pathogens, in part by releasing secondary metabolites [11,12,13,14,15]. Additionally, arthropods that encounter fungal propagules present within the plant may suffer harm, or even death. However, some evidence shows that the presence of fungal conidia within the plant is uncommon. This lends additional support to the hypothesis that antibiosis occurs via secondary metabolites—which act as a deterrent rather than by fungal propagules [16].
Crops have been successfully endophytically colonized using a variety of EPF and inoculation methods. The use of EPF as endophytes for insect pest control was pioneered by Lewis and Bing [17], who were able to suppress European corn borer, Ostrinia nubilalis Hübner (Lepidoptera: Crambidae), populations in corn using Beauveria bassiana (Bals.-Criv.) Vuill. (Ascomycota: Hypocreales). This fungal species has been the most used in studies involving inoculation and colonization of crops [8] such as cotton, tomato, common bean, strawberry, coffee, sweet pepper, corn, sorghum, and potato, among others [18,19,20,21,22,23,24,25,26]. Successful colonization has been achieved using various inoculation methods, such as foliar sprays, seed soaking, and soil drenching. Inoculation methods may be differentially effective depending on the plant species, and may also influence the localization of the fungus. For example, a foliar spray may be more effective for the inoculation of leaves, while a soil drench may be more effective for roots [13,15,27]. Biotic and abiotic factors, such as soil microorganisms or temperature, and other variables can influence the fungal endophytic colonization of a crop. In addition, inoculation methods, growth medium, fungal species, conidial concentration, crop age, and crop cultivar have all been reported to influence colonization effectiveness [13].
The citrus industry in Florida faces challenges from multiple arthropod pests, with the most important being the Asian citrus psyllid (Diaphorina citri Kuwayama; Hemiptera: Liviidae), the main vector that spreads the pathogen associated with citrus greening (Huanglongbing, HLB) [28,29]. Other common pests include aphids, whiteflies, scales, weevils, and mites [30]. The need to manage arthropod pests in citrus agroecosystems, has led to a dependency on frequent applications of synthetic chemical insecticides, which has resulted in arthropods developing resistance and secondary pest resurgence [28,31,32]. Additionally, these intensive chemical applications have caused a decrease in the biodiversity and abundance of beneficial insects in agroecosystems [32]. Therefore, more management strategies that are sustainable and economically viable need to be researched [33].
Although there is increasing interest in the applications of EPF as endophytes, the number of studies incorporating them into citrus is marginal. Given the numerous arthropod pests and pathogens that challenge the citrus industry, it would be beneficial to increase the knowledge about inoculating citrus plants with these fungi. The applications of EPF can be used in a sustainable and integrated pest management strategy. Our objective in this study was to determine the potential endophytic colonization of plant tissues with B. bassiana in different citrus rootstocks, using different inoculation methods. This information would be an important first step in determining the potential application and efficacy of endophytic fungal entomopathogens in the citrus industry, principally for the control of damaging arthropod pests.
2. Materials and Methods
2.1. Fungal Strain and Conidial Stock Suspension
Beauveria bassiana strain PPRI 5339, contained in the EPF-based biopesticide Velifer® ES (BASF SE, Florham Park, NJ, USA), was used for this study. To prepare the conidial stock suspension, 1 mL of Velifer was diluted in 100 mL of sterile deionized H2O and stirred with a magnetic stir bar for 30 min. The conidial concentration of the dilution was determined to be 2 × 106 conidia mL−1 by using a Neubauer Improved C-Chip hemacytometer (INCYTO Co., Ltd., Cheonan, Chungnam, Korea). Then, 100 µL of the dilution was pipetted onto potato dextrose agar (PDA) plates amended with streptomycin sulfate and chloramphenicol and spread with a sterilized bent-glass rod (according to Avery et al. [34]). The top cover was replaced; plates were then sealed with Parafilm “M”® (Bemis Inc., Neenah, WI, USA) and placed in a growth chamber at 25 °C with a 14 h photophase for 2 weeks. This process was repeated weekly to ensure an adequate supply of conidia for inoculation methods and trial repetitions. Conidial viability was determined to be greater than 95% for all experiments.
After 2 weeks in the growth chamber, the plates were removed, and the conidia were harvested. This was achieved by flooding each PDA plate with 15 mL of 0.01% Tween 80 solution, and the agar surface was gently scraped with a flame-sterilized, bent-glass rod (Millipore-Sigma, Burlington, MA, USA) to release the conidia. Each plate suspension was then carefully poured through four layers of sterile cheesecloth into individual 200 mL Erlenmeyer flasks to filter out hyphal fragments from the conidia. The concentration of this suspension was adjusted to 4 × 107 conidia mL−1. This conidial stock suspension was used in each of the inoculation methods, which included foliar spray, soil drench, and seed soaking.
2.2. Plant Material
Three citrus rootstocks were used in this experiment. The seedlings were grown and obtained from the Southern Citrus Nurseries (Dundee, FL, USA). The rootstock genotypes were US-812 (Citrus reticulata ‘Sunki’ × Poncirus trifoliata ‘Benecke’), US-942 (C. reticulata ‘Sunki’ × P. trifoliata ‘Flying Dragon’), and Swingle citrumelo (C. paradisi Macfad × P. trifoliata (L.) Raf.). All seedlings (32 for each genotype) were 6 months old when received. They were immediately transferred to one-gallon black plastic pots filled with washed and dry-heated ‘All-natural Pure Play’TM sand (Sakrete of North America LLC., Charlotte, NC, USA) and were given 12 g of Osmocote® 15-9-12 fertilizer (The Scotts Company LLC., Marysville, OH, USA). To accurately simulate natural soil conditions, the sand was not sterilized. Although this may potentially lead to competition with the B. bassiana spores and other microorganisms, it also is more reflective of field conditions. The pots were arranged in a greenhouse using a split-plot experimental design, and the plants were given 5 weeks to re-acclimate before commencing inoculations. During this time, they were watered twice a day (~30 mL min−1 each time) using a drip irrigation system, and lateral shoots were pruned as needed.
2.3. Plant Inoculations
The rootstocks in the greenhouse were inoculated with the conidial stock suspension. The conidial concentration for both foliar spray and soil drench treatments was 4 × 107 conidia mL−1. Both the foliar spray and soil drench treatment groups consisted of 24 plants, with 12 treated and 12 control each.
2.3.1. Foliar Spray
A Nalgene® hand pump sprayer (Nalgene Nunc International, Rochester, NY, USA) was used to apply a total of 150 mL of 0.01% Tween 80 with B. bassiana conidia (4 × 107 conidia mL−1) to the treated group, while the control group received only 150 mL of 0.01% Tween 80. Each plant received approximately 12 mL of inoculum. The pots were covered with aluminum foil prior to spraying to prevent conidia from contaminating the soil surface. There were 12 plants sprayed with conidia and 12 control, and the process was repeated twice. To assess the efficacy of the foliar spray technique, leaf conidial deposition was determined by pinning coverslips to the adaxial and abaxial surfaces of leaves prior to spraying per rootstock. The plastic cover slips were allowed to dry for 24 h and then removed from the leaf and pinned into a Styrofoam® lid. Each cover slip was prepared using the protocol of Avery, Kumar, Skvarch, Mannion, Powell, McKenzie, and Osborne [34] and observed under a stereo light microscope (Leica ICC50 E, Leica, Wetzlar, Germany) with a digital camera. Images were taken at 400× magnification to count the number of conidia per mm2. Fiji imaging software [35] was used to provide quantification of conidia. In addition, three leaves per tree were collected and pressed (adaxial and abaxial surfaces) onto PDA plates amended with selective fungicide dodine (PDA–dodine), before and after spray treatment to visually assess coverage of the spray.
2.3.2. Soil Drench
Each plant in the soil drench treatment received 35 mL of fungal inoculum (4 × 107 conidia mL−1) in 0.01% Tween 80, and control plants received only 0.01% Tween 80. The inoculum or the Tween 80 was applied to the soil surface at the base of the plant directly around the stem using a battery-powered pipette (BrandTech, Essex, CT, USA). To assess the efficacy of the soil drench technique using a drip irrigation system, allowing the B. bassiana conidia to leach downward through the moist sand to the root depth, soil core samples were taken with a modified 25 mL plastic pipette [36] prior to destructive sampling of the plants. Two core samples from each pot were taken by pressing a modified 25 mL plastic pipette with the tip sawed off into the moist sand to obtain a core sample. These cores were then assessed to determine the presence and concentration in colony-forming units (CFUs) of B. bassiana conidia at varying depths in the soil. The core sample was divided into bottom, middle, and upper depth levels by sawing the pipette into three 4 ± 1 cm sections. Sand from the same depth levels and rootstock genotypes were combined and mixed in Ziploc® bags (S.C. Johnson and Son, Racine, WI, USA). Ten-gram random samples were taken from the bags, placed in 50 mL plastic tubes (VWR, Radnor, PA, USA) with 30 mL of deionized water, and vortexed for 30 s [27]. Ten individual aliquots of 100 µL were then removed from the supernatant, and each was spread onto separate PDA–dodine plates using a flame-sterilized, bent-glass rod. The top covers were replaced, plates were sealed with Parafilm, randomly arranged on a plastic cafeteria tray, and placed in the same growth chamber in the environmental conditions stated above. Plates were observed daily for approximately 1.5 weeks to visually observe and count CFUs of B. bassiana amongst the other fungi.
2.4. Seed Inoculation
Similar to the seedlings, a total of 264 seeds (88 from each rootstock) were used for the experiment. Seeds were obtained from the nursery mentioned above. After being soaked in water for 24 h, the seeds were surface sterilized by soaking in 70% ethanol for 3 min, followed by 2% sodium hypochlorite for 3 min, and were then rinsed with sterile deionized water three times [27]. Aliquots of 100 µL of the final rinse water were spread onto PDA plates amended with selective fungicide (dodine and the previously mentioned antibiotics), and top covers were replaced. They were sealed with Parafilm, randomly arranged on a cafeteria tray, and placed into the same growth chamber in the environmental conditions stated above. After 2 weeks, the plates were checked for fungal contamination to determine if sterilization was successful. This process was performed in 12 batches so that samples showing contamination could be excluded.
The seeds from each batch were then evenly spaced on a moistened paper towel in large 150 mm sterile empty glass Pyrex® Petri dish (Corning Inc., Corning, NY, USA), top covers were replaced, and Petri dishes were sealed with Parafilm to initiate germination. Sealed dishes were placed in the dark at room temperature (~23 °C). Three weeks after seed germination had been initiated, each batch of seeds were soaked in a conidial suspension at a concentration of 4 × 107 conidia mL−1 for 24 h. Soaked seeds were then sown in seedling trays (SureRoots50®, T.O. Plastics, Inc., Clearwater, MN, USA) filled with the same sand mentioned above. Seeds were allowed to grow and were watered as needed over the course of 8 weeks. Afterwards, the sprouted seedlings were harvested for destructive sampling to determine if B. bassiana was endophytic in the roots, stems, and leaves.
2.5. Assessing Fungal Colonization of Plant Material
After 7 weeks, plants were harvested, destructively sampled, and root, leaf, and stem samples were collected and surface sterilized. The bulk sterilization protocol developed by Greenfield et al. [37] was used to process large volumes of plant samples by soaking them in 70% ethanol for 2 min, followed by soaking them in 2% sodium hypochlorite for 3 min. After sterilization, the plant samples were rinsed with sterile, deionized water three times, and 100 µL of the final rinsate was spread onto PDA–dodine plates. The top covers replaced; they were sealed with Parafilm and then placed in the same growth chamber as above under the same environmental conditions. This process was to confirm successful sterilization of the organs with no contamination from saprophytic fungi. Mature leaves from the mid-section of the plant were also pressed onto PDA–dodine plates and processed as described above to assess if B. bassiana propagules had remained on the surface after sterilization.
Roots, mature, and newly emerged leaves (where mature leaves are the ones that were present at the time of the fungal application and newly emerged leaves are the ones that developed post-application) and stems were trimmed after sterilization to remove edges where the sterilization process may have negatively affected endophytic B. bassiana. Trimmed samples were then placed onto PDA–dodine plates and processed as described above. Root samples (~5 cm) were divided into root tips (~1 cm) and upper roots (~4 cm from root tip), and leaves were divided into upper (towards the apex), lower leaf (towards the petiole), and newly emerged leaves sections. Similarly, four pieces (~1 cm) of the stems were cut from the mid-section of the plant. The plant samples were placed and arranged as described inside of Petri dishes, processed as described above, and put into the same growth chamber under the environmental conditions described above. After 2 weeks in the growth chamber, the plates were removed and observed for phenotypic fungal growth of B. bassiana deriving from the plant samples. A pure colony of B. bassiana was used as a template to compare against the other fungi. Similar endophyte colonies were compared morphologically both under a stereo microscope (Leica EZ4E, Leica, Wetzlar, Germany) (colony morphology) and under a stereo light microscope (described above) for phenotypic morphology to confirm whether an outgrowth was indeed B. bassiana. Additionally, due to suspected B. bassiana strain PPRI 5339 outgrowth, agar plugs containing the outgrowth were removed from plates using a flame-sterilized cork borer, cultured on separate PDA–dodine plates, and processed as described above for additional comparison. A count was recorded for each occurrence of B. bassiana outgrowth from the plant samples.
2.6. Statistical Analysis
One-way ANOVA and Tukey’s tests were used to determine differences in CFU counts between soil layers. Significance for all tests was set as p ≤ 0.05. The R software was used for data analysis (https://www.r-project.org/, accessed on 18 July 2022).
3. Results
3.1. Fungal Re-Isolation
None of the control plants showed signs of endophytic colonization by B. bassiana. Overall, attempts at re-isolating endophytic B. bassiana from various sections of plant tissue resulted in five successful re-isolations from 126 treated plants and seeds (Table 1). Of these five samples, three occurred in the foliar spray treatment (24 treated plants) and two in the seed soaking treatment (75 treated seeds), while no samples from the soil drench treatment displayed endophytism by B. bassiana, regardless of rootstock genotype. Of the three positive samples in the foliar spray group, one appeared in roots from US-942 and one in new flush (leaves that sprouted after spraying), while the third appeared in US-812 from a sprayed leaf sample (Figure 1). The two B. bassiana endophytic samples from the seed soaking method were observed growing from the stem pieces of US-812 and US-942. Tissue samples from the treated Swingle rootstocks did not yield any endophytism of B. bassiana.
Table 1.
Colonization frequency of Beauveria bassiana in different plant organs (leaves, roots, and stem) of three citrus rootstocks. Data were collected seven weeks after application of 4 × 107 conidia mL−1.
Figure 1.
Successful re-isolation of endophytic entomopathogenic fungus Beauveria bassiana (strain PPRI 5339 contained in Velifer®) from different plant organs of three citrus rootstocks (Swingle, US-812 and US-942): (A) leaf, (B) stem, and (C) root tissue. Data were collected seven weeks after application of 4 × 107 conidia mL−1. Plant sections were surface sterilized, placed on potato dextrose agar plates amended with streptomycin, chloramphenicol, and dodine. Plates were placed in a growth chamber at 25 °C and with 14 h photophase. After 2 weeks, plates were removed and assessed for fungal outgrowth from plant samples. (A,C) are from foliar-spray-treated US-812 and US-942, respectively. (B) is from the seed-soak treatment of US-942. No re-isolation of endophytic Beauveria bassiana was observed with the Swingle rootstock.
3.2. Plant Inoculation Methods
Leaf presses showed that the foliar spray effectively coated the adaxial and abaxial sides of leaves with active conidia. Plants sprayed with conidia showed distinct fungal colony growth within the outline after pressing leaves onto PDA–dodine plates (Figure 2).
Figure 2.
Sample image of leaf presses on potato dextrose agar plates amended with streptomycin, chloramphenicol, and dodine. Citrus leaves were foliar sprayed with Beauveria bassiana (Strain PPRI 5339 contained in Velifer®). Image was taken 14 days after spraying.
The mean number (±SD) of conidia per mm2 on cover slips that were pinned to the leaves was 45.69 (SD = 107.41), and there was no significant difference in mean number of conidia between cover slips on adaxial and abaxial surfaces of the leaves (Figure 3).
Figure 3.
Conidial deposition of Beauveria bassiana (strain PPRI 5339 contained in Velifer®) on a plastic cover slip that was acid fuchsin stained and photographed at 400× magnification.
The soil cores revealed that the top layer of the soil had significantly (F = 92.30; df = 2, 82; p < 0.0005) higher quantities of CFUs compared to the bottom and middle layers of the soil (Table 2). There was no significant difference per rootstock between the number of CFUs in the top and middle layers of the soil. In the bottom layers, more CFUs were observed per plate with rootstocks US-942 and US-812, compared to Swingle. Plants in the control groups did not have any observed CFUs of B. bassiana.
Table 2.
Mean number of colony-forming units (CFUs) of Beauveria bassiana (Strain PPRI 5339 contained in Velifer®). Soil cores samples were taken from moist sandy soil after 6 weeks post-inoculation via soil drench. Sample cores were taken from each pot and divided into three equal depths (bottom, middle, and top), and suspensions were made. Ten samples from each suspension were spread onto potato dextrose agar plates amended with streptomycin, chloramphenicol, and dodine. Results are categorized by citrus rootstock. No CFUs of B. bassiana were observed in any of the control rootstock groups.
4. Discussion
In this study, a strain of the entomopathogenic fungi B. bassiana was applied to three different citrus rootstocks using three inoculation methods. This was carried out to determine if this strain could become endophytic in citrus, to what degree or frequency it was successful, as well as which inoculation methods and rootstock cultivar had the highest occurrence of fungal endophytism by B. bassiana. In doing so, this study explored the potential application of using fungal entomopathogens as endophytes in citrus agroecosystems and nursery production for the purpose of biological arthropod pest control and other potential benefits, such as increased disease resistance.
We found that this strain of B. bassiana had a low occurrence or incidence rate in becoming endophytic in these citrus rootstocks tested using different inoculation methods, but nonetheless still demonstrated potential colonization in planta under optimal environmental conditions. No plants in the soil drench group had re-isolated B. bassiana, while three plants in the foliar spray group and two plants in the seed soaking group displayed fungal endophytism in our tissue samples. Within the foliar spray group, B. bassiana was re-isolated from root and leaf tissue samples, as well as newly emerged leaves, demonstrating systemic movement of the fungal endophyte. A similar study involving B. bassiana foliar-spray-inoculated lemon seedlings reported a colonization percentage of tissue samples as high as 60% and 43% for leaves, and 36% and 24% for stems at 7 and 80 days post-inoculation, respectively [38]. In cotton plants treated by soaking seeds in a conidial suspension, B. bassiana was reisolated from 33 to 66% of sampled plants at different growth stages [39]. Using a soil drench inoculation on cassava plants, Greenfield et al. [40] reported that 84% of treated plants were colonized at 7 to 9 days after inoculation, which dropped to 40% at 47 to 49 days after inoculation. Numerous other studies using B. bassiana and other entomopathogenic fungi to inoculate a variety of crop species have reported high percentages of colonization of plants by these fungi, along with a general trend of decreasing endophytism over time [13].
There are multiple plausible reasons as to why a greater amount of endophytism by B. bassiana was not observed in the citrus rootstocks used in this study. These include (but are not limited to) potting substrate, fungal strain, plant species, plant age and health, competition with other endophytes, and surface sterilization protocols [13,20,41]. The rootstocks were already 7 months old when inoculated with B. bassiana, and re-isolations were only carried out 7 weeks after inoculations. Bamisile et al. [42] showed that lemon seedlings that were 6 months old were less effectively colonized than seedlings that were 3 months old. Furthermore, while B. bassiana has been shown to persist in some woody plant species for over 6 months [22,43], this fungal endophyte has also been observed to be less effective over time, which can be influenced by plant species and fungal strain interactions, among other factors [40].
The potting medium used can also influence endophytic colonization success, with non-sterile soil showing lower colonization success of B. bassiana compared to sterile soil and vermiculite [25]. The potting medium used in this study was not sterilized; therefore, the sandy soil may have contained antagonistic microorganisms that would have competed with the endophytism of B. bassiana. Parsa et al. [20], found that the potting substrate used has a strong influence on the outcome of potential endophytic colonization following seed soaking of the common bean, and predictable colonization rates are unlikely under natural microbial soil conditions. There is high variability in the colonization success rates of the numerous EEPF applied to different crop species. This suggests that the interaction between plant cultivars and EPF plays a major role in determining the efficacy of employing the EPF as endophytes [44].
Our results align with findings from similar studies in which inoculation method and plant species/genotype influenced the success of endophytic colonization, and the migration of B. bassiana to areas outside of the inoculated region [45]. However, this movement was observed in un-grafted rootstocks. Whether B. bassiana is able to move internally past the grafting union of a citrus rootstock and scion has not been tested. The pathway for internal movement of the endophyte could be through air spaces between parenchyma cells or through the plants’ vascular tissue [46].
No fungal growth was detected from any plants within the soil drench treatment, which may be due to the conidia not leaching through the soil deeply enough to reach the roots zone in significant quantities. Soil cores taken from the pots showed that the top 3–5 cm of soil contained significantly higher amounts of B. bassiana conidia compared to the middle and bottom layers of the soil. This may have resulted in an insufficient number of conidia reaching the roots of the plant to successfully colonize them. Meanwhile, three plants in the foliar spray treatment had B. bassiana re-isolated from samples. Additionally, within those foliar-spray-treated plants, the fungus was recovered from both stem and root tissue, demonstrating that it is possible for the endophyte to move systemically within the plant. Furthermore, B. bassiana was only re-isolated from US-812 and US-942 rootstocks and not from Swingle rootstocks. A clear reason for this is not known; it may be by chance or due to interactions with this strain of B. bassiana and the Swingle rootstock.
5. Conclusions
As an endophyte, the entomopathogen B. bassiana shows promise not only as a sustainable means for arthropod pest control, but also in providing plants with other benefits such as increased nutrient uptake, disease resistance, plant growth, and general plant health. This study shows that inoculating citrus rootstocks with B. bassiana is possible using certain inoculation methods, but more research is needed to increase endophytic colonization rates and determine their benefits. Factors such as environmental conditions and the age of trees might prove challenging when it comes to implementing the usage of endophytic B. bassiana in commercial citrus operations. Using B. bassiana as an endophyte may be more applicable in a nursery production setting, and future research may focus on this.
Author Contributions
Conceptualization, L.R. and P.B.A.; methodology, P.B.A.; investigation, M.A. and E.B.D.; resources, L.R. and P.B.A.; statistical analysis, M.A.; writing—original draft preparation, M.A.; writing—review and editing, L.R., M.A. and P.B.A.; supervision, L.R. and P.B.A.; funding acquisition, L.R. and P.B.A. All authors have read and agreed to the published version of the manuscript.
Funding
This research was funded by U.S. Department of Agriculture (USDA), National Institute of Food and Agriculture, Hatch project #FLA-IRC-005743. Florida Department of Agriculture and Consumer Services contract #27971; NIFA/USDA Multi-State Hatch Research Project #FLA-IRC-005729; S1070: The Working Group on Improving Microbial Control of Arthropod Pests.
Institutional Review Board Statement
Not applicable.
Informed Consent Statement
Not applicable.
Data Availability Statement
The data presented in this study are available within this article. Raw data are available upon request to the corresponding author (l.rossi@ufl.edu).
Acknowledgments
We thank Southern Citrus Nurseries (Dundee, FL, USA) for providing us with plant materials. We are also grateful to Laura Muschweck and John-Paul Fox for assistance with treatment application and data collection.
Conflicts of Interest
The authors declare no conflict of interest.
References
- Shah, P.A.; Pell, J.K. Entomopathogenic fungi as biological control agents. Appl. Microbiol. Biotechnol. 2003, 61, 413–423. [Google Scholar] [CrossRef] [PubMed]
- Fernandes, E.G.; Valerio, H.M.; Feltrin, T.; Van Der Sand, S.T. Variability in the production of extracellular enzymes by entomopathogenic fungi grown on different substrates. Braz. J. Microbiol. 2012, 43, 827–833. [Google Scholar] [CrossRef] [PubMed]
- Altinok, H.H.; Altinok, M.A.; Koca, A.S. Modes of action of entomopathogenic fungi. Curr. Trends Nat. Sci. 2019, 8, 117–124. [Google Scholar]
- Mantzoukas, S.; Eliopoulos, P.A. Endophytic Entomopathogenic Fungi: A Valuable Biological Control Tool against Plant Pests. Appl. Sci. 2020, 10, 360. [Google Scholar] [CrossRef]
- Litwin, A.; Nowak, M.; Różalska, S. Entomopathogenic fungi: Unconventional applications. Rev. Environ. Sci. Bio/Technol. 2020, 19, 23–42. [Google Scholar] [CrossRef]
- López, Ó.; Fernández-Bolaños, J.G.; Gil, M.V. New trends in pest control: The search for greener insecticides. Green Chem. 2005, 7, 431–442. [Google Scholar] [CrossRef]
- Vega, F. The use of fungal entomopathogens as endophytes in biological control: A review. Mycologia 2018, 110, 4–30. [Google Scholar] [CrossRef]
- Moraga, E.Q. Entomopathogenic fungi as endophytes: Their broader contribution to IPM and crop production. Biocontrol Sci. Technol. 2020, 30, 864–877. [Google Scholar] [CrossRef]
- Faeth, S.H.; Fagan, W.F. Fungal Endophytes: Common Host Plant Symbionts but Uncommon Mutualists. Integr. Comp. Biol. 2002, 42, 360–368. [Google Scholar] [CrossRef]
- Rodriguez, R.J.; White, J.F., Jr.; Arnold, A.E.; Redman, R.S. Fungal endophytes: Diversity and functional roles. New Phytol. 2009, 182, 314–330. [Google Scholar] [CrossRef]
- Jaber, L.R.; Ownley, B.H. Can we use entomopathogenic fungi as endophytes for dual biological control of insect pests and plant pathogens? Biol. Control 2018, 116, 36–45. [Google Scholar] [CrossRef]
- Ownley, B.H.; Gwinn, K.D.; Vega, F.E. Endophytic fungal entomopathogens with activity against plant pathogens: Ecology and evolution. BioControl 2010, 55, 113–128. [Google Scholar] [CrossRef]
- Bamisile, B.S.; Dash, C.K.; Akutse, K.S.; Keppanan, R.; Afolabi, O.G.; Hussain, M.; Qasim, M.; Wang, L. Prospects of endophytic fungal entomopathogens as biocontrol and plant growth promoting agents: An insight on how artificial inoculation methods affect endophytic colonization of host plants. Microbiol. Res. 2018, 217, 34–50. [Google Scholar] [CrossRef] [PubMed]
- Vega, F.E. Insect pathology and fungal endophytes. J. Invertebr. Pathol. 2008, 98, 277–279. [Google Scholar] [CrossRef]
- Kaushik, H.; Dutta, P. Establishment of Metarhizium anisopliae, an entomopathogen as endophyte for biological control in tea. Res. Crop. 2016, 17, 375. [Google Scholar] [CrossRef]
- Vega, F.E.; Posada, F.; Aime, M.C.; Pava-Ripoll, M.; Infante, F.; Rehner, S.A. Entomopathogenic fungal endophytes. Biol. Control 2008, 46, 72–82. [Google Scholar] [CrossRef]
- Lewis, L.; Bing, L.A. Bacillus thuringiensis berliner and Beauveria bassiana (balsamo) vuillimen for european corn borer control: Program for immediate and season-long suppression. Can. Entomol. 1991, 123, 387–393. [Google Scholar] [CrossRef]
- Lopez, D.C.; Zhu-Salzman, K.; Ek-Ramos, M.J.; Sword, G.A. The Entomopathogenic Fungal Endophytes Purpureocillium lilacinum (Formerly Paecilomyces lilacinus) and Beauveria bassiana Negatively Affect Cotton Aphid Reproduction under Both Greenhouse and Field Conditions. PLoS ONE 2014, 9, e103891. [Google Scholar] [CrossRef]
- Powell, W.A.; Klingeman, W.; Ownley, B.; Gwinn, K.D. Evidence of Endophytic Beauveria bassiana in Seed-treated Tomato Plants Acting as a Systemic Entomopathogen to Larval Helicoverpa zea (Lepidoptera: Noctuidae). J. Entomol. Sci. 2009, 44, 391–396. [Google Scholar] [CrossRef]
- Parsa, S.; Ortiz, V.; Gómez-Jiménez, M.I.; Kramer, M.; Vega, F.E. Root environment is a key determinant of fungal entomopathogen endophytism following seed treatment in the common bean, Phaseolus vulgaris. Biol. Control 2016, 116, 74–81. [Google Scholar] [CrossRef]
- Dara, S.K.; Dara, S.R.; Dara, S.S. Endophytic colonization and pest management potential of Beauveria bassiana in strawberries. J. Berry Res. 2013, 3, 203–211. [Google Scholar] [CrossRef]
- Posada, F.; Aime, M.C.; Peterson, S.W.; Rehner, S.A.; Vega, F.E. Inoculation of coffee plants with the fungal entomopathogen Beauveria bassiana (Ascomycota: Hypocreales). Mycol. Res. 2007, 111, 748–757. [Google Scholar] [CrossRef] [PubMed]
- Jaber, L.R.; Araj, S.-E. Interactions among endophytic fungal entomopathogens (Ascomycota: Hypocreales), the green peach aphid Myzus persicae Sulzer (Homoptera: Aphididae), and the aphid endoparasitoid Aphidius colemani Viereck (Hymenoptera: Braconidae). Biol. Control 2018, 116, 53–61. [Google Scholar] [CrossRef]
- Wagner, B.L.; Lewis, L.C. Colonization of Corn, Zea mays, by the Entomopathogenic Fungus Beauveria bassiana. Appl. Environ. Microbiol. 2000, 66, 3468–3473. [Google Scholar] [CrossRef] [PubMed]
- Tefera, T.; Vidal, S. Effect of inoculation method and plant growth medium on endophytic colonization of sorghum by the entomopathogenic fungus Beauveria bassiana. BioControl 2009, 54, 663–669. [Google Scholar] [CrossRef]
- Jones, K.D. Aspects of the Biology and Biological Control of the European Corn Borer in North Carolina. Ph.D. Thesis, North Carolina State University, Ann Arbor, MI, USA, 1995. [Google Scholar]
- Doherty, E.; Avery, P.; Duren, E.; Cano, L.; Rossi, L. In Planta Localization of Endophytic Cordyceps fumosorosea in Carrizo Citrus. Microorganisms 2021, 9, 219. [Google Scholar] [CrossRef] [PubMed]
- Graham, J.; Gottwald, T.; Setamou, M. Status of Huanglongbing (HLB) outbreaks in Florida, California and Texas. Trop. Plant Pathol. 2020, 45, 265–278. [Google Scholar] [CrossRef]
- Bové, J.M. Huanglongbing: A destructive, newly-emerging, century-old disease of citrus. J. Plant Pathol. 2006, 88, 7–37. [Google Scholar]
- Michaud, J.P. Classical Biological Control: A Critical Review of Recent Programs Against Citrus Pests in Florida. Ann. Entomol. Soc. Am. 2002, 95, 531–540. [Google Scholar] [CrossRef]
- Chen, X.D.; Gill, T.A.; Pelz-Stelinski, K.S.; Stelinski, L.L. Risk assessment of various insecticides used for management of Asian citrus psyllid, Diaphorina citri in Florida citrus, against honey bee, Apis mellifera. Ecotoxicology 2017, 26, 351–359. [Google Scholar] [CrossRef]
- Boina, D.R.; Bloomquist, J.R. Chemical control of the Asian citrus psyllid and of huanglongbing disease in citrus. Pest Manag. Sci. 2015, 71, 808–823. [Google Scholar] [CrossRef]
- Killiny, N.; Jones, S.E.; Nehela, Y.; Hijaz, F.; Dutt, M.; Gmitter, F.G.; Grosser, J.W. All roads lead to Rome: Towards understanding different avenues of tolerance to huanglongbing in citrus cultivars. Plant Physiol. Biochem. 2018, 129, 1–10. [Google Scholar] [CrossRef] [PubMed]
- Avery, P.B.; Kumar, V.; Skvarch, E.A.; Mannion, C.M.; Powell, C.A.; McKenzie, C.L.; Osborne, L.S. An Ecological Assessment of Isaria fumosorosea Applications Compared to a Neonicotinoid Treatment for Regulating Invasive Ficus Whitefly. J. Fungi 2019, 5, 36. [Google Scholar] [CrossRef] [PubMed]
- Schindelin, J.; Arganda-Carreras, I.; Frise, E.; Kaynig, V.; Longair, M.; Pietzsch, T.; Preibisch, S.; Rueden, C.; Saalfeld, S.; Schmid, B.; et al. Fiji: An open-source platform for biological-image analysis. Nat. Methods 2012, 9, 676–682. [Google Scholar] [CrossRef]
- Avery, P.B.; Hunter, W.B.; Hall, D.G.; Jackson, M.A.; Powell, C.A. Efficacy of Topical Application, Leaf Residue or Soil Drench of Blastospores of Isaria fumosorosea for Citrus Root Weevil Management: Laboratory and Greenhouse Investigations. Insects 2016, 7, 66. [Google Scholar] [CrossRef] [PubMed]
- Greenfield, M.; Pareja, R.; Ortiz, V.; Gómez-Jiménez, M.I.; Vega, F.E.; Parsa, S. A novel method to scale up fungal endophyte isolations. Biocontrol Sci. Technol. 2015, 25, 1208–1212. [Google Scholar] [CrossRef]
- Aguila, L.C.R.; Akutse, K.S.; Bamisile, B.S.; Moreano, J.P.S.; Ashraf, H.J.; Zhou, C.; Li, X.; Wang, L. Endophytically colonized Citrus limon seedlings by Beauveria bassiana hampered development, reproduction and progeny fitness of Diaphorina citri. J. Appl. Entomol. 2021, 146, 229–242. [Google Scholar] [CrossRef]
- Sword, G.A.; Tessnow, A.; Ek-Ramos, M.J. Endophytic fungi alter sucking bug responses to cotton reproductive structures. Insect Sci. 2017, 24, 1003–1014. [Google Scholar] [CrossRef]
- Greenfield, M.; Gómez-Jiménez, M.I.; Ortiz, V.; Vega, F.E.; Kramer, M.; Parsa, S. Beauveria bassiana and Metarhizium anisopliae endophytically colonize cassava roots following soil drench inoculation. Biol. Control 2016, 95, 40–48. [Google Scholar] [CrossRef]
- Russo, M.; Pelizza, S.; Vianna, M.; Allegrucci, N.; Cabello, M.; Toledo, A.; Mourelos, C.; Scorsetti, A. Effect of endophytic entomopathogenic fungi on soybean Glycine max (L.) Merr. growth and yield. J. King Saud Univ. Sci. 2019, 31, 728–736. [Google Scholar] [CrossRef]
- Bamisile, B.S.; Akutse, K.S.; Dash, C.K.; Qasim, M.; Aguila, L.C.R.; Ashraf, H.J.; Huang, W.; Hussain, M.; Chen, S.; Wang, L. Effects of Seedling Age on Colonization Patterns of Citrus limon Plants by Endophytic Beauveria bassiana and Metarhizium anisopliae and Their Influence on Seedlings Growth. J. Fungi 2020, 6, 29. [Google Scholar] [CrossRef] [PubMed]
- Brownbridge, M.; Reay, S.D.; Nelson, T.L.; Glare, T.R. Persistence of Beauveria bassiana (Ascomycota: Hypocreales) as an endophyte following inoculation of radiata pine seed and seedlings. Biol. Control 2012, 61, 194–200. [Google Scholar] [CrossRef]
- Vidal, S.; Jaber, L.R. Entomopathogenic fungi as endophytes: Plant-endophyte-herbivore interactions and prospects for use in biological control. Curr. Sci. 2015, 109, 46–54. [Google Scholar]
- Bamisile, B.S.; Dash, C.K.; Akutse, K.S.; Qasim, M.; Aguila, L.C.R.; Wang, F.; Keppanan, R.; Wang, L. Endophytic Beauveria bassiana in Foliar-Treated Citrus limon Plants Acting as a Growth Suppressor to Three Successive Generations of Diaphorina citri Kuwayama (Hemiptera: Liviidae). Insects 2019, 10, 176. [Google Scholar] [CrossRef]
- Lefort, M.-C.; McKinnon, A.; Nelson, T.L.; Glare, T. Natural occurrence of the entomopathogenic fungi Beauveria bassiana as a vertically transmitted endophyte of Pinus radiata and its effect on above- and below-ground insect pests. PeerJ PrePrints 2016, 4, e1632v1. [Google Scholar] [CrossRef]
Publisher’s Note: MDPI stays neutral with regard to jurisdictional claims in published maps and institutional affiliations. |
© 2022 by the authors. Licensee MDPI, Basel, Switzerland. This article is an open access article distributed under the terms and conditions of the Creative Commons Attribution (CC BY) license (https://creativecommons.org/licenses/by/4.0/).